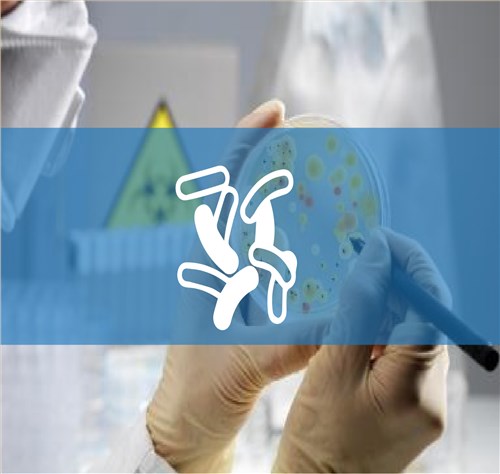
微生物检测实验室解决方案

微生物检测实验室常用仪器设备解决方案
| 序号 | 设备名称 | 功能介绍 | 推荐品牌 |
| 1 | 生物安全柜 | 为操作原代培养物、菌毒株以及诊断性标本等具有感染性的实验材料时,用来保护操作者本人、实验室环境以及实验材料 | |
| 2 | 双人单面垂直送风净化工作台 | 准闭合式玻璃风门,可有效防止外部气流透入,及操作异味对人体的刺激 | |
| 3 | 电热恒温培养箱 | 水体分析和BOD测定细菌、霉菌、微生物的培养、保存、植物栽培、育种试验的专用恒温设备 | 博讯,森信 |
| 4 | 低温生化培养箱 | 培养血清、药品、微生物培养环境试验的专用低温设备 | |
| 5 | 电热恒温鼓风干燥箱 | 用于物品的烘焙,干燥,热处理和热加工、农业生产,科学研究,医疗卫生单位,实验实均可使用 | |
| 6 | 高压灭菌锅 | 采用电加热水,在密闭的条件下,产生饱和蒸汽,对灭菌对象迅速潮润、加热、渗透,经一段时间的保压保温。使微生物被杀灭,达到灭菌目的 | |
| 7 | 双目显微镜 | 应用了光学原理的显微放大技术,对采集的细微样品制作成标本,进行显微技术的放大和观察 | 宁波舜宇 |
| 8 | 万分之一电子分析天平(内校) | 性能更加稳定,且反应速度更快,同时具有积分可调和稳定度、灵敏度可调功能 | 奥豪斯 |
| 9 | 便携式PH计|酸度计|酸度检测仪 | 实验室精密测量溶液pH值和电极电位 | 奥豪斯,三信,雷磁 |
| 10 | 实用型实验室专用纯水机 | 采用预处理、反渗透技术、超纯化处理以及后级处理等方法,将水中的导电介质去除 | 上海和泰 |
| 11 | 恒温水浴锅 | 水浴恒温加热和其它温度试验 | 一恒,博讯,森信,亚荣 |
| 12 | 六级筛孔撞击式空气微生物采样器 | 双功能阶式多级撞击采样器 | |
| 13 | 全自动旋转振荡器 | 实验室样品前处理 | 奥豪斯,一恒,梅洁 |


 400-0027-510
400-0027-510
一次性医用口罩,纳米级疫情专用防护口罩
一次性医用口罩,纳米级疫情专用防护口罩 一次性医用手套,疫情专用防护手套
一次性医用手套,疫情专用防护手套 酒精消毒液,75%乙醇,疫情防护消毒酒精
酒精消毒液,75%乙醇,疫情防护消毒酒精 84消毒液,疫情防护消毒液
84消毒液,疫情防护消毒液 免洗消毒洗手液,疫情防护专用洗手液
免洗消毒洗手液,疫情防护专用洗手液 额温枪,红外人体测温仪
额温枪,红外人体测温仪 医用外科口罩,平面型,内装1片
医用外科口罩,平面型,内装1片 组织培养实验室解决方案
组织培养实验室解决方案 质量安全实验室解决方案
质量安全实验室解决方案 公共卫生实验室解决方案
公共卫生实验室解决方案